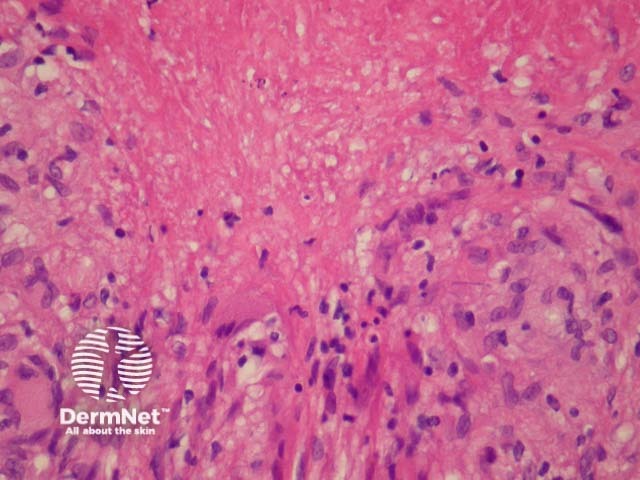
Figure 4

Main menu
Common skin conditions

NEWS
Join DermNet PRO
Read more
Quick links
Author: Assoc Prof Patrick Emanuel, Dermatopathologist, Auckland, New Zealand, 2013.
Lupus miliaris disseminatus faciei (LMDF) is an uncommon facial dermatosis. It presents with pale papules which may be confused with sarcoid or syringoma clinically. Many authors now consider LMDF to be an extreme variant of granulomatous rosacea, rather than a mycobacterial infection as previously thought.
In LMDF, sections show round granulomas with central caseating necrosis. The granulomas may appear sarcoidal or tuberculoid. The granulomas typically arise adjacent to adnexal structures. A chronic infiltrate often accompanies the granulomas. See figures 1-4.

Figure 1

Figure 2

Figure 3
Figure 4
Mycobacterial and fungal infections may be ruled out with special stains (Ziehl Neelson and GMS respectively). PCR and culture studies may be used if an infection is suspected.
Granulomatous syphilis, deep fungal infection, leishmaniasis, tuberculosis – PCR and culture studies may be needed for the distinction in difficult cases.
Sarcoidosis – Typically lacks caseating necrosis but may show some fibrinoid degeneration within the granulomas which can cause confusion.
Granulomatous rosacea – Some authorities believe LMDF is a form of rosacea. The degree of necrosis would be unusual for rosacea